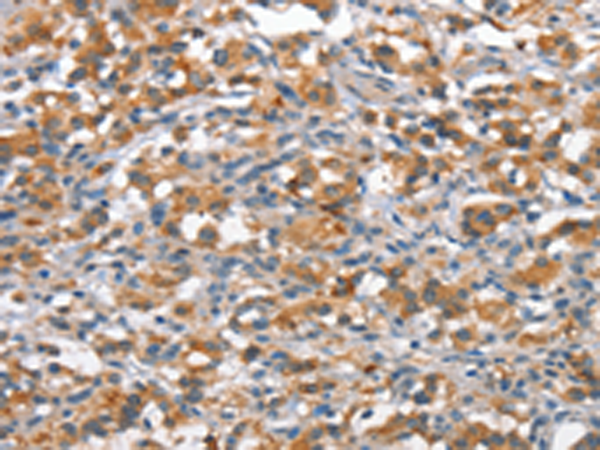

中文名稱: 兔抗ANP32C多克隆抗體
英文名稱: Anti-ANP32C rabbit polyclonal antibody
別 名: PP32R1
相關類別: 一抗
儲 存: 冷凍(-20℃)
宿 主: Rabbit
抗 原: ANP32C
反應種屬: Human
標 記 物: Unconjugate
克隆類型: rabbit polyclonal
技術規格
| ackground: | Phosphoprotein 32 (PP32) is a tumor suppressor that can inhibit several types of cancers, including prostate and breast cancers. The protein encoded by this gene is one of at least two proteins that are similar in amino acid sequence to PP32 and are part of the same acidic nuclear phosphoprotein gene family. However, unlike PP32, the encoded protein is tumorigenic. The tumor suppressor function of PP32 has been localized to a 25 amino acid region that is divergent between PP32 and the protein encoded by this gene. This gene does not contain introns. |
| Applications: | ELISA, IHC |
| Name of antibody: | ANP32C |
| Immunogen: | Synthetic peptide of human ANP32C |
| Full name: | acidic (leucine-rich) nuclear phosphoprotein 32 family, member C |
| Synonyms: | PP32R1 |
| SwissProt: | O43423 |
| ELISA Recommended dilution: | 1000-2000 |
| IHC positive control: | Human thyroid cancer and Human brain |
| IHC Recommend dilution: | 25-100 |
購物車
購物車 幫助
幫助
 021-54845833/15800441009
021-54845833/15800441009
